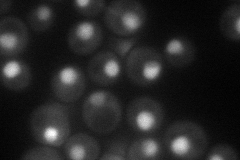
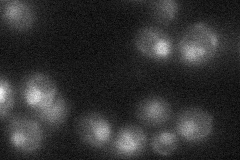

View description
Protein required for accurate chromosome segregation during meiosis
Localization:
Intensity:
Fold change:
Significance:
-
C’ GFP library in SD

nucleus17.96 -
N' NOP1pr-GFP in SD
nucleus61.8366 -
N' TEF2pr-mCherry in SD

nucleus41.1422 -
N' NATIVEpr-GFP in SD
nucleus29.0674 -
N' TEF2pr-VC and Cyto-VN in SD

#N/A0 -
C’ GFP library in SD+DTT

nucleus160.89No -
C’ GFP library in SD+H2O2

nucleus16.10.89No -
C’ GFP library in Starvation Media

nucleus16.710.93No -
C’ GFP library on the background of Pup2-DaMP

nucleus -
C’ GFP library on the background of CCT mutant

nucleusN/AN/ANo
